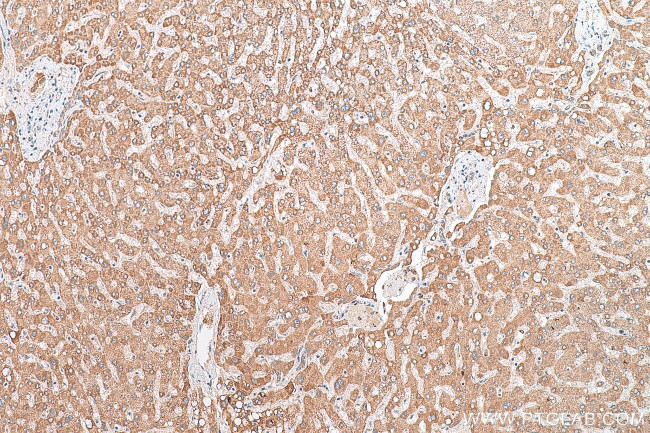
BCKDHA Antibody in Immunohistochemistry (Paraffin) (IHC (P))

Search
Proteintech
BCKDHA Polyclonal Antibody
{{$productOrderCtrl.translations['antibody.pdp.commerceCard.promotion.promotions']}}
{{$productOrderCtrl.translations['antibody.pdp.commerceCard.promotion.viewpromo']}}
{{$productOrderCtrl.translations['antibody.pdp.commerceCard.promotion.promocode']}}: {{promo.promoCode}} {{promo.promoTitle}} {{promo.promoDescription}}. {{$productOrderCtrl.translations['antibody.pdp.commerceCard.promotion.learnmore']}}
产品信息
30028-1-AP
种属反应
宿主/亚型
分类
类型
抗原
偶联物
形式
纯化类型
保存液
内含物
保存条件
运输条件
产品详细信息
Immunogen sequence: CRNNGYAIST PTSEQYRGDG IAARGPGYGI MSIRVDGNDV FAVYNATKEA RRRAVAENQP FLIEAMTYRI GHHSTSDDSS AYRSVDEVNY WDKQDHPISR LRHYLLSQGW WDEEQEKAWR KQSRRKVMEA FEQAERKPKP NPNLLFSDVY QEMPAQLRKQ QESLARHLQT YGEHYPLDHF DK
靶标信息
The BCKDHA gene encodes the E1-alpha subunit of the branched-chain alpha-keto acid (BCAA) dehydrogenase complex (BCKD; EC 1.2.4.4), an inner-mitochondrial enzyme complex that catalyzes the oxidative decarboxylation of the branched-chain alpha-ketoacids derived from isoleucine, leucine, and valine. This reaction is the second major step in the catabolism of the branched-chain amino acids (Wynn et al., 1998). The BCKD complex consists of 3 catalytic components: a heterotetrameric (alpha2-beta2) branched-chain alpha-keto acid decarboxylase (E1), a homo-24-meric dihydrolipoyl transacylase (E2), and a homodimeric dihydrolipoamide dehydrogenase (E3). E1 is a thiamine pyrophosphate (TPP)-dependent enzyme. The reaction is irreversible and constitutes the first committed step in BCAA oxidation. The BCKDHB gene encodes the beta subunit of E1. The complex also contains 2 regulatory enzymes, a kinase and a phosphorylase.
仅用于科研。不用于诊断过程。未经明确授权不得转售。
篇参考文献 (0)
生物信息学
蛋白别名: 2-oxoisovalerate dehydrogenase (lipoamide); 2-oxoisovalerate dehydrogenase subunit alpha, mitochondrial; BCKAD E1[a]; BCKDE1A; BCKDH E1-alpha; branched chain alpha-ketoacid dehydrogenase subunit E1 alpha; branched chain keto acid dehydrogenase E1 alpha protein; branched chain keto acid dehydrogenase E1, alpha polypeptide; branched chain keto acid dehydrogenase subunit E1, alpha polypeptide; Branched-chain alpha-keto acid dehydrogenase E1 component alpha chain; branched-chain alpha-keto acid dehydrogenase E1-alpha subunit; unnamed protein product
基因别名: BCKDA; BCKDE1A; BCKDHA; E1a; MSU; MSUD1; MSUD1A; OVD1A
UniProt ID: (Human) P12694, (Rat) P11960
Entrez Gene ID: (Human) 593, (Rat) 25244, (Mouse) 12039